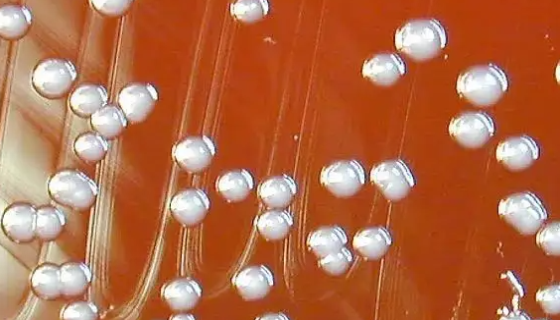
洋葱伯克霍尔德菌的培养方法及使用范围！

植物乳杆菌的保健作用与执行标准及注意事项!
植物乳杆菌是乳酸菌的一种,具有很多的保健作用,如下:①有一定...

TF-1(人血液白血病细胞)的培养与传代方法!
人血液白血病细胞的培养与传代方法及注意事项有哪些?

枯草芽孢杆菌的作用与使用方法及应用领域!
枯草芽孢杆菌,是芽孢杆菌属的一种。作为一种安全、高效、多功能...
洋葱伯克霍尔德菌的培养方法及使用范围!
洋葱伯克霍尔德菌(Burkholderia cepacia)...

HB人口腔癌细胞收到后的处理方法与培养步骤!
人口腔癌细胞收到后的处理方法与培养步骤以及需要注意的事项有哪...

大鼠脑皮层神经元细胞培养实验的方法与步骤!
神经元是具有长突触(轴突)的细胞,它由细胞体和细胞突起构成。...

大肠埃希氏菌的种类与特征及检测方法!
大肠埃希氏菌一般指大肠杆菌。是条件致病菌,在一定条件下可以引...

小鼠脑微血管内皮细胞株的处理方法与培养步骤!
小鼠脑微血管内皮细胞株收到后的处理方法和培养步骤有哪些?

表皮葡萄球菌的生物学性状与微生物学检查!
表皮葡萄球菌(Staphylococcus epidermi...